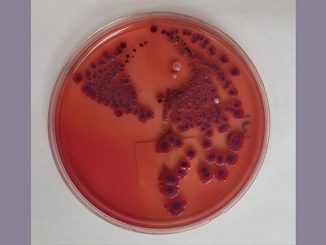

Researchers identify a gene that drives T lymphocytes to exhaustion
A research group funded by the Swiss National Science Foundation has identified a gene that drives T lymphocytes to exhaustion. […]
A research group funded by the Swiss National Science Foundation has identified a gene that drives T lymphocytes to exhaustion. […] LONDON/GENEVA (Reuters) – Governments may have to reserve drugs and vaccines for the World Health Organization to distribute in poorer […] Potentially lifesaving steroids commonly given to preterm babies also increase the risk of long-term cardiovascular problems, but a new study […] We don’t need a doctor to tell us that sitting for long hours is bad for our health. Now a […] Oral vitamin D supplementation nearly halved the rates of suicide and intentional self-harm in a study of US veterans, with […] Using talking therapies to effectively treat depression in adults over the age of 65 may be clinically linked with slightly […] According to study published in the American Journal of Roentgenology (AJR), MRI-based surveillance after surgical treatment of musculoskeletal soft-tissue sarcomas […] In a recent article published in Emerging Infectious Diseases, researchers examined a prospective cohort of frontline workers in the United States […] A genomic study of a sustained, multidrug-resistant Shigellosis outbreak in Seattle enabled scientists to retrace its origin and spread. Additional […] Do YOU know what counts towards your five a day? As ANOTHER study warns of dangers of junk food, here’s […]Health News

Researchers identify a gene that drives T lymphocytes to exhaustion

Draft WHO Pandemic Deal Pushes for Equity to Avoid COVID ‘Failure’

Combined steroid and statin treatment could reduce ‘accelerated aging’ in preterm babies

Sitting all day? Science says there’s an easy way to counteract the harmful effects

Vitamin D Supplementation Linked to Fewer Suicide Attempts

Researchers assess link between talking therapy and lower rates of dementia

MRI surveillance for postsurgical musculoskeletal soft-tissue sarcomas: Systematic review and meta-analysis

Risk factors for Omicron reinfections among previously infected frontline workers in the United States
Genomic methods aid study of Seattle 2017-2022 Shigella outbreak

Do YOU know what counts towards your five a day?
Copyright © 2026